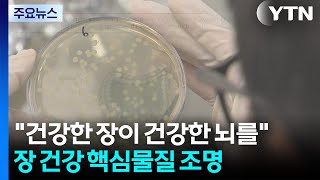
\ 건강한 장이 건강한 뇌 만든다\ ...장 건강 핵심물질 조명 / YTN

[부음] 최영희(핀포인트뉴스 증권·중소기업부 부국장)씨 장모상


DOWN
평택시 TV/동영상 뉴스
-
사회
‘하반기 경기 살리기 통큰 세일’… 21개 상권 참여
-
경제
경기경제청, 평택 포승지구에 자동차부품 제조사 3곳 유치. 400억 원 대 투자
-
경제
경기경제청, 평택·제조기업 3곳과 포승지구 투자협약 체결
-
문화
용인 동학농민혁명정신 선양사업 위한 과제와 계획
-
평택시 21개 상권, 22~30일 '경기살리기 통큰 세일' 참여
-
사회
평택소방서, ‘어린이 불조심 포스터 공모전’ 개최
-
경제
경기도 평택 포승지구에 자동차 부품 제조기업 3곳 408억원 투자
-
사회
평택시의회, 노동정책 연구용역 최종보고회
-
국제
기아, 인증중고차 센터 평택 직영점 및 PBV 익스피리언스 센터 개소
-
사회
평택시의회, ‘인공지능(AI) 정책연구회’ 최종보고회 개최
-
정치
2025년 평택시 항만발전자문위원회 개최
-
사회
평택시, ‘하반기 경기 살리기 통큰 세일’ 참여
-
사회
홍기원 의원, 평택시장애인부모회 애로사항 청취
-
사회
평택시의회 ‘평택시 노동정책 연구회’ 최종보고회 개최
-
정치
평택시, ‘2025년 항만발전자문위원회’ 열어
-
중고차 실물 보고 시승까지 해보세요
-
사회
제10회 평택시장기 경기도장애인역도대회 진행
-
사회
평택권 21개 상권 참여, 지역화폐 최대 20% 보상 혜택
-
사회
평택시, ‘하반기 경기 살리기 통큰 세일’에 21개 상권참여
-
정치
2025년 평택시 항만발전자문위원회 개최
-
정치
평택시, 항만 탈탄소 위한 자문회의 개최
-
정치
'제22기 민주평화통일자문회의 평택시협의회' 출범식
-
IT
평택시, ‘노점 행위 일제 정비’ 실시
-
사회
대한적십자사봉사회 평택시협의회, 취약계층 대상 김장김치 나눔 진행
-
사회
경기도, 세계 최대 반도체 메가 클러스터 조성에 나서
-
경제
경기경제청 총 408억 투자유치
-
교육
SBI저축은행, 고령층 대상 금융사기 예방교육
평택시 언론지수
전체보기평택시 사설/칼럼
평택시 인터뷰
평택시 추천 콘텐츠
-
두영배
평택시, 내년 예산 2조4283억원 편성

-
김성서
[속보] 이달 1~20일 수출 8.2% 증가...무역수지 24억 달러 흑자

-
김성서
[종합] 11월 1~20일 수출 8.2% 증가...'관세 협상 마무리' 美 수출 5.7%↑

-
평택자치신문
평택직할세관, 2025년 10월 ‘수출 3.2%↓, 수입 5.1%↓’ 밝혀

-
평택자치신문
[2025 국민연금 문답] 노후준비 방법으로 국민연금이 유리하나요?

-
두영배
평택시 안중읍 지역사회보장협의체, ‘세탁해드림’과 ‘행복 꾸러미’ 전달

-
임순만
경기도형 ESG 자활정책 ‘라라워시’ 평택점 28일 개소

-
정재신
경기도형 ESG 자활 정책 '라라워시' 평택점 28일 문 열어. 자활근로자 15명 채용

-
뉴시스
"환경 보호, 취약계층 자립"…경기도, '라라워시' 평택점 문연다

-
평택자치신문
[정재우 칼럼] 미래세대에게 고함

함께 만드는 지역정보
평택시 NEW 미디어
-

‘이종섭 호주도피’ 尹 추가기소…“숨진 공무원 특검 감찰 맹탕” / KBS 2025.11.27.
1시간전 -
건강한 장이 건강한 뇌 만든다 ...장 건강 핵심물질 조명 / YTN
1시간전 -

43일 만에 인양된 실종 여성 차량…전 연인 살해 자백 / KBS 2025.11.27.
1시간전 -

악재 쏟아지는 민선 8기 후반전…전환점 마련할까? / KBS 2025.11.28.
1시간전 -
![꼭꼭 숨겨도 찾는다…탐지견 ‘알콩이’ [대담한K] / KBS 2025.11.28.](https://img.youtube.com/vi/fStUa7nmjBg/mqdefault.jpg)
꼭꼭 숨겨도 찾는다…탐지견 ‘알콩이’ [대담한K] / KBS 2025.11.28.
1시간전 -

홍콩 화재 사망 65명으로 늘어...27시간 만에 진화 / YTN
1시간전 -

국민의힘, '재개발 주택 사전매입' 조병길 사상구청장 제명 확정 / YTN
1시간전 -

검찰 ‘패트 사건’ 항소 포기…‘검사 집단 퇴정’ 논란, 감찰 대상? / KBS 2025.11.27.
1시간전 -
![노인과 바다의 뿔치가 제주 바당에!…“신바람” [그때 제주는] / KBS 2025.11.28.](https://img.youtube.com/vi/KxMK4jH90Bo/mqdefault.jpg)
노인과 바다의 뿔치가 제주 바당에!…“신바람” [그때 제주는] / KBS 2025.11.28.
1시간전


































